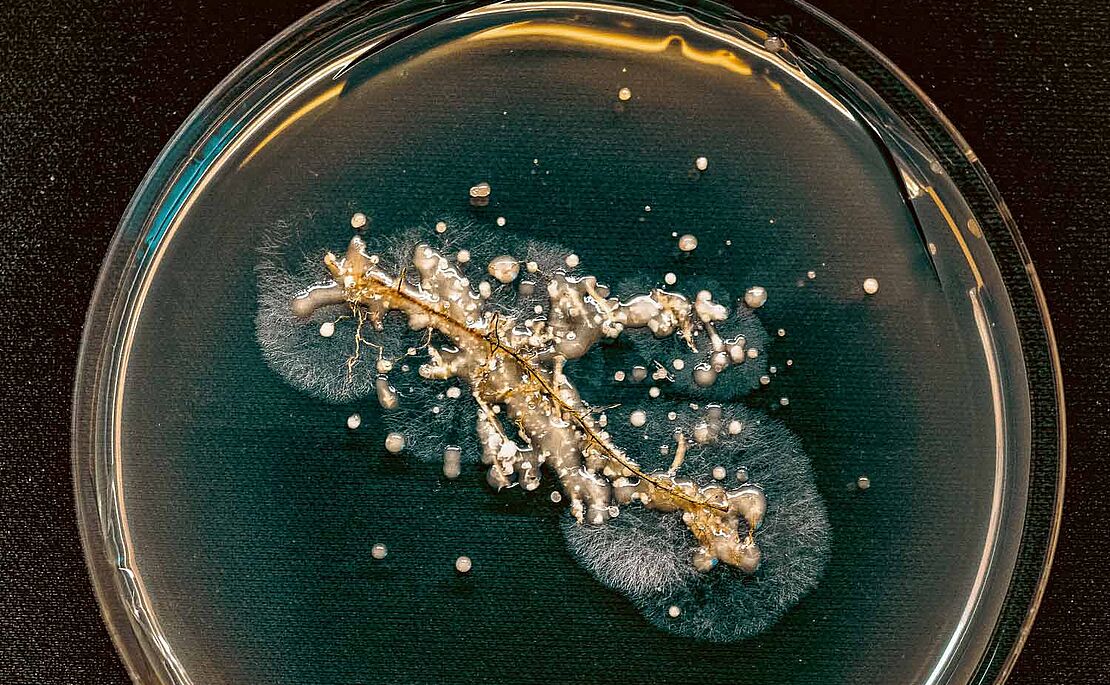
Pilzsporen in einer Petrischale

Psychische Gesundheit am Arbeitsplatz
Hauptinhalt
Unternehmen & Karriere

Onlineplattform
Finanzbildung für Kinder und Teenager

Apotheken-App
Medikamente sichern, bevor man losfährt

Organisationsentwicklung
Unternehmensgärten für Mitarbeiter

Strategie: Firmenübernahme
Die Innungsmeisterin als flotte Lead-Sängerin

Marcel Haraszti, Rewe International AG
Der Mann hinter Billa und Co.

Branchengespräch